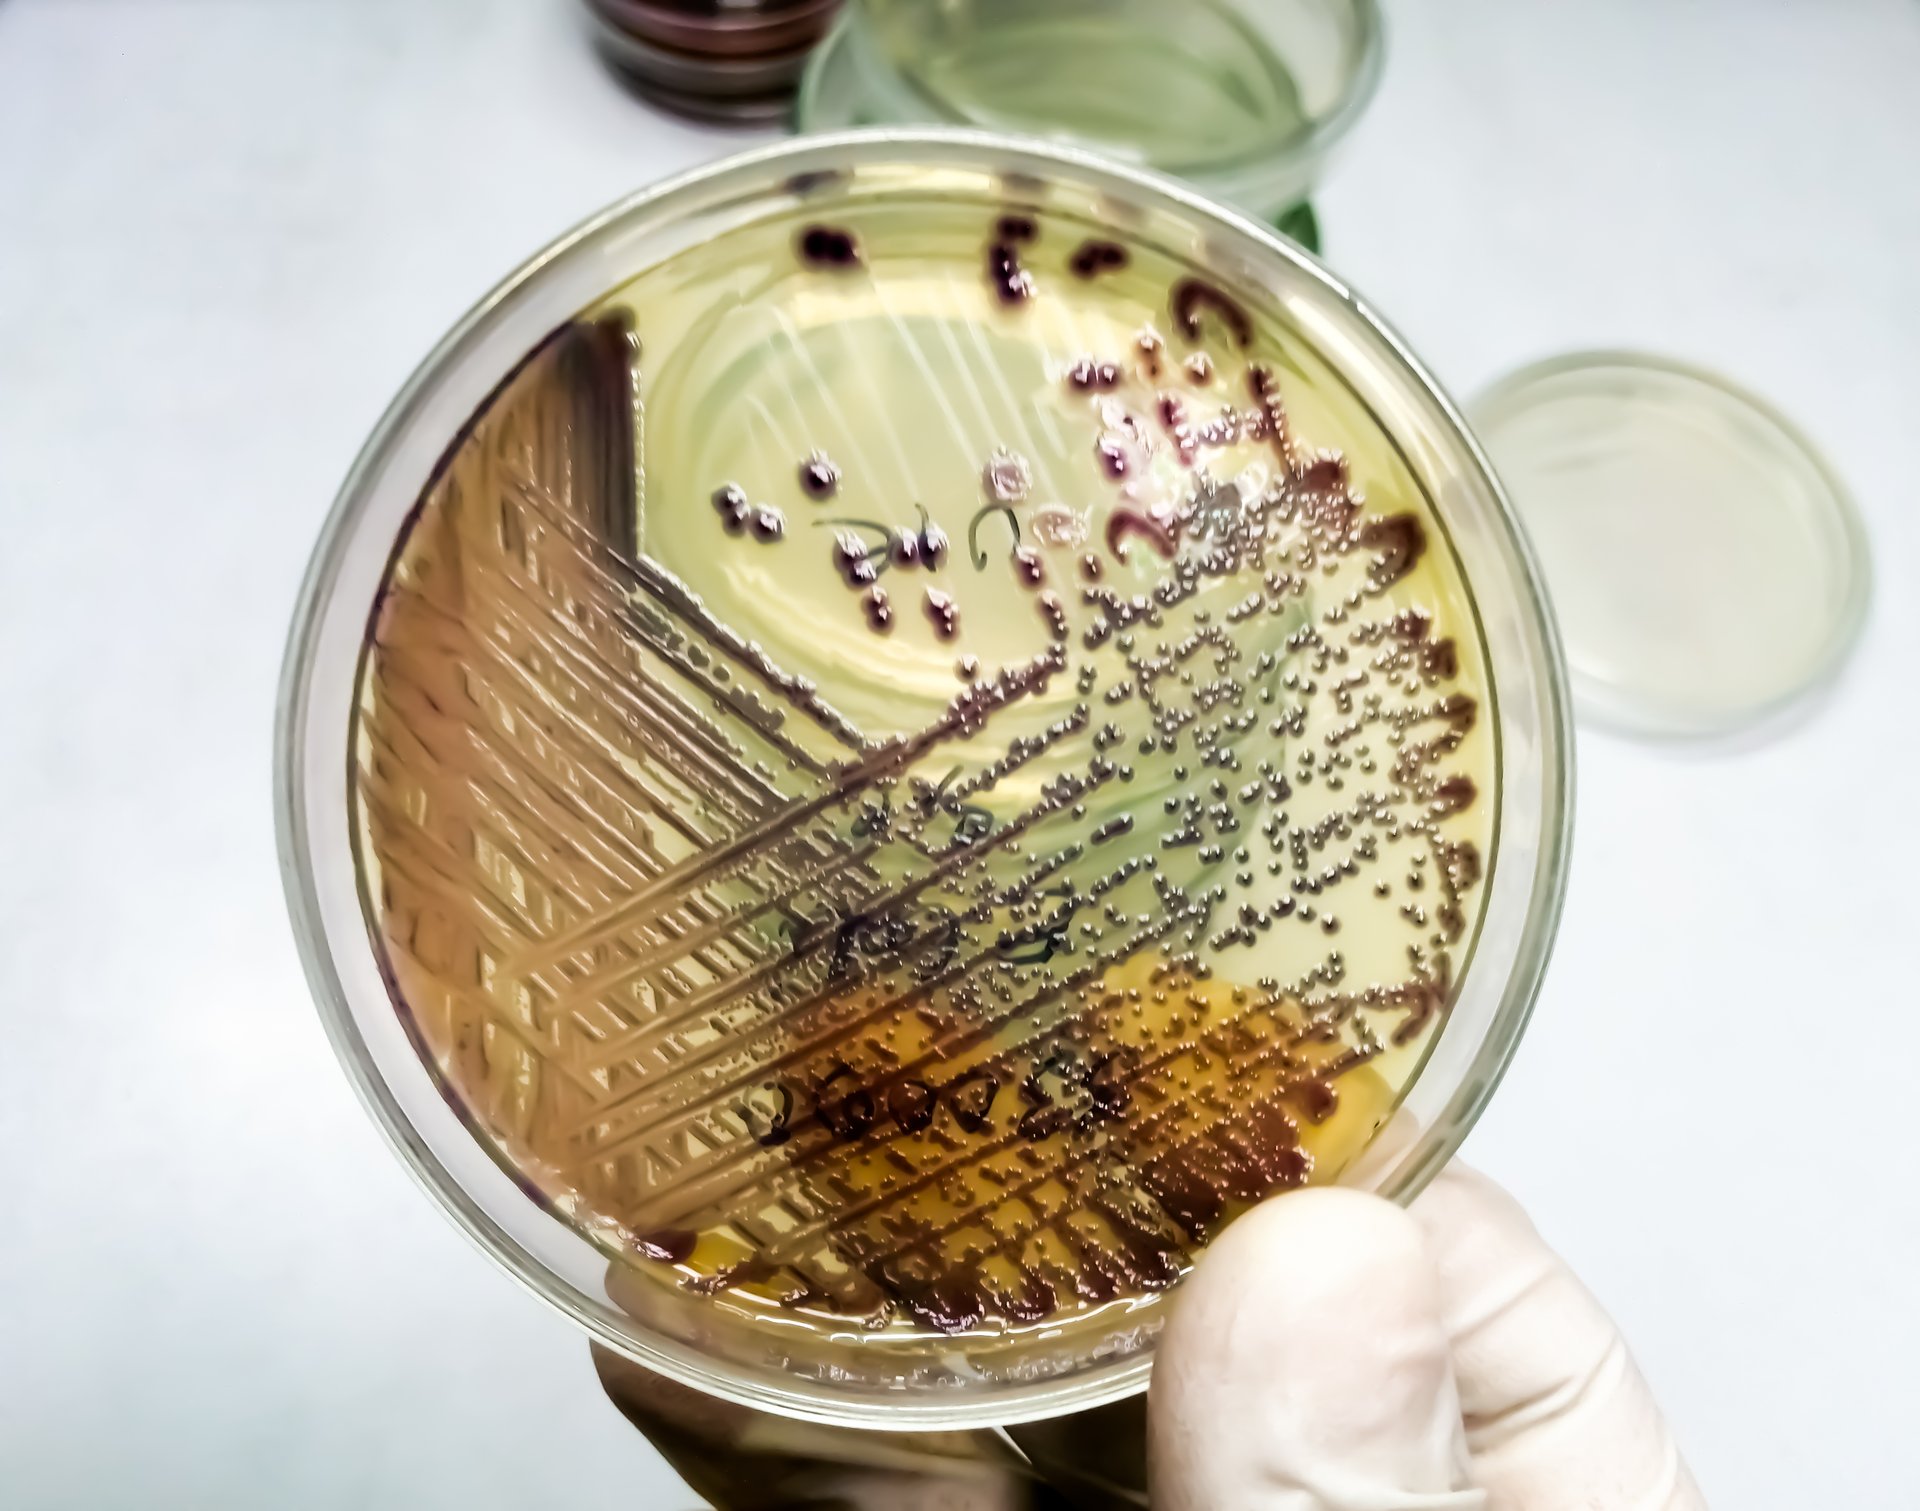
bacteria-colony-of-escherichia-coli-or-ecoli-in-culture-media-plate (1)

En Alicia en el país de las maravillas hay un momento en el que Alicia y la Reina Roja corren a toda velocidad. Es entonces cuando la primera nota que, a pesar de no parar de correr, siempre permanecen en el mismo sitio.
—Pero ¿cómo? ¡Si parece que hemos estado bajo este árbol todo el tiempo! ¡Todo está igual que antes! —dice Alicia.
—Aquí es preciso correr mucho para permanecer en el mismo lugar —responde la Reina.
Esta escena inspiró el nombre de lo que se conoce en biología como la hipótesis de la Reina Roja. Propone que los organismos deben estar en continua evolución para mantener su statu quo en el entorno.
Un ecosistema microscópico en nuestro intestino
Las bacterias son ubicuas y se han encontrado en todos los ambientes donde alguna vez alguien las ha buscado: desde las calientes fuentes termales de Yellowstone o las ácidas aguas del río Tinto a los fríos lagos del Antártico.
Uno de los ecosistemas bacterianos más poblados del planeta se encuentra en el intestino humano: se estima que contiene al menos tantas células humanas como bacterianas. Allí conviven un sinfín de seres microscópicos, entre los que destacan las bacterias. El conjunto de microorganismos que habitan en nuestro intestino se conoce como microbiota o flora intestinal.
La microbiota intestinal es fundamental para nuestra salud. Sabemos que los cambios en la comunidad bacteriana están asociados a una amplia gama de enfermedades, que incluyen el cáncer, enfermedades inflamatorias y el trastorno depresivo, entre otras. Además, los microbios de nuestro intestino pueden actuar de barrera contra la infección de bacterias patógenas. Así pues, es fundamental comprender cómo cambian y evolucionan esos microorganismos para entender su impacto en nuestra salud.
Seres en permanente cambio
Las bacterias evolucionan principalmente mediante un fenómeno conocido como “transferencia horizontal”, que permite el intercambio de genes entre microorganismos no emparentados. Uno de los principales agentes involucrados en este proceso son los plásmidos, moléculas de ADN que se encuentran distribuidas en la práctica totalidad de especies bacterianas.
Mediante el intercambio o la captación de plásmidos, las bacterias pueden adquirir nuevas funciones de forma rápida, lo cual les confiere una gran capacidad de adaptarse a cambios en el ambiente.
Desafortunadamente, una de las funciones que pueden adquirir las bacterias vía plásmidos es la capacidad de resistir a los antibióticos, las sustancias capaces de inhibir su crecimiento.
Antes del descubrimiento de estos fármacos, las enfermedades asociadas a las bacterias eran una de las principales causas de muerte. Tras el descubrimiento y el posterior uso clínico de los antibióticos, las infecciones bacterianas pasaron a un segundo plano.
Además, el uso de antibióticos ha permitido alcanzar importantes avances en la medicina, como cirugías o tratamientos que deprimen el sistema inmune. Son fundamentales para sostener la medicina moderna.
No obstante, la capacidad de las bacterias de evolucionar en respuesta a los tratamientos ha impulsado la aparición de resistencias. Este fenómeno se ha convertido en una amenaza especialmente importante en ambientes clínicos.
Los antibióticos de último recurso
Aunque existen muchos tipos de antibióticos, muchos de ellos son ya ineficaces para tratar infecciones comunes. Con el fin de lograr la máxima eficiencia y controlar el desarrollo de resistencias, el uso de algunos de estos medicamentos está limitado.
Los antibióticos carbapenémicos, que se emplean como tratamientos de última opción terapéutica, funcionan precisamente para tratar infecciones por bacterias resistentes a múltiples antibióticos. No obstante, también se han detectado microorganismos que han evolucionado para ser resistentes a estos compuestos.
En nuestro grupo de investigación, y en colaboración con el Instituto Ramón y Cajal de Investigación Sanitaria, nos preguntamos cómo se diseminan y evolucionan las bacterias resistentes a los antibióticos carbapenémicos. Para ello, aislamos bacterias del intestino de más de 9 000 pacientes de un hospital madrileño a lo largo de cuatro años. Esto nos permitió seguir la transmisión y evolución de los microorganismos.
En un primer estudio, identificamos zonas de contagio entre pacientes. Observamos que una vez una bacteria resistente llega al intestino de una persona, ésta es capaz de transmitir su resistencia a otras bacterias de la microbiota del paciente. Este proceso ocurre mediante la transferencia horizontal, mediada por plásmidos que contienen genes de resistencia.
Entonces, el individuo puede contagiar la bacteria resistente a otro individuo y volver a iniciar el proceso de transmisión. En esta dinámica, es muy importante el papel de un grupo de plásmidos llamados pOXA-48: su intercambio permite a las bacterias volverse resistentes a los antibióticos carbapenémicos.
Por este motivo, en un segundo estudio nos centramos en entender el modo en que evolucionan las bacterias una vez han recibido este tipo de plásmidos. Nuestros resultados muestran cómo los antibióticos administrados a cada paciente afectaron la forma de evolucionar de los plásmidos, afectando a su vez a la evolución de las bacterias que los portan.
Más allá del tubo de ensayo
Louis Pasteur creó el primer medio de cultivo bacteriano a mediados del siglo XIX. Su descubrimiento y optimización ha permitido el desarrollo de la microbiología; hoy en día constituye una herramienta fundamental en cualquier laboratorio de este campo de investigación, ya que permite aislar y hacer crecer a las bacterias.
En los medios de cultivo podemos hacer evolucionar bacterias y poder así estudiar su adaptación a diferentes ambientes. Este tipo de experimentos ha aumentado nuestra comprensión de sus dinámicas evolutivas y nos permite ver cómo estas responden a cuestiones importantes que afectan a la salud humana.
Sin embargo, los factores que actúan sobre las poblaciones bacterianas en entornos reales son mucho más complejos que los que pueden estudiarse en el laboratorio. En ecosistemas como el intestino humano entran en juego múltiples factores como tratamientos médicos, cambios en la dieta o la interacción de las bacterias con el sistema inmune.
Hoy en día, los avances en las tecnologías de secuenciación y manipulación del ADN nos abren una puerta a estudiar la evolución de estos microorganimos en sus ecosistemas reales. Cada vez más estudios demuestran la importancia de integrar conceptos evolutivos en todos los campos de la lucha contra el avance de las bacterias resistentes: desde el diagnóstico clínico al diseño de nuevos fármacos y posibles tratamientos.
Sabemos que las bacterias poseen una capacidad sorprendente de adaptación a nuevos ambientes. Esta capacidad hace que, por mucho que las tratemos con antibióticos, finalmente aparecerán bacterias resistentes.
Volviendo a Alicia en el país de las maravillas, las bacterias están corriendo constantemente para poder sobrevivir. Entender en qué dirección y a qué velocidad lo hacen nos puede dar una gran ventaja al permitir anticiparnos a sus posibles efectos negativos en nuestra salud.
Javier de la Fuente Hidalgo. Investigador, Centro Nacional de Biotecnología (CNB - CSIC)
Este artículo fue originalmente publicado en The Conversation bajo la licencia Creative Commons.